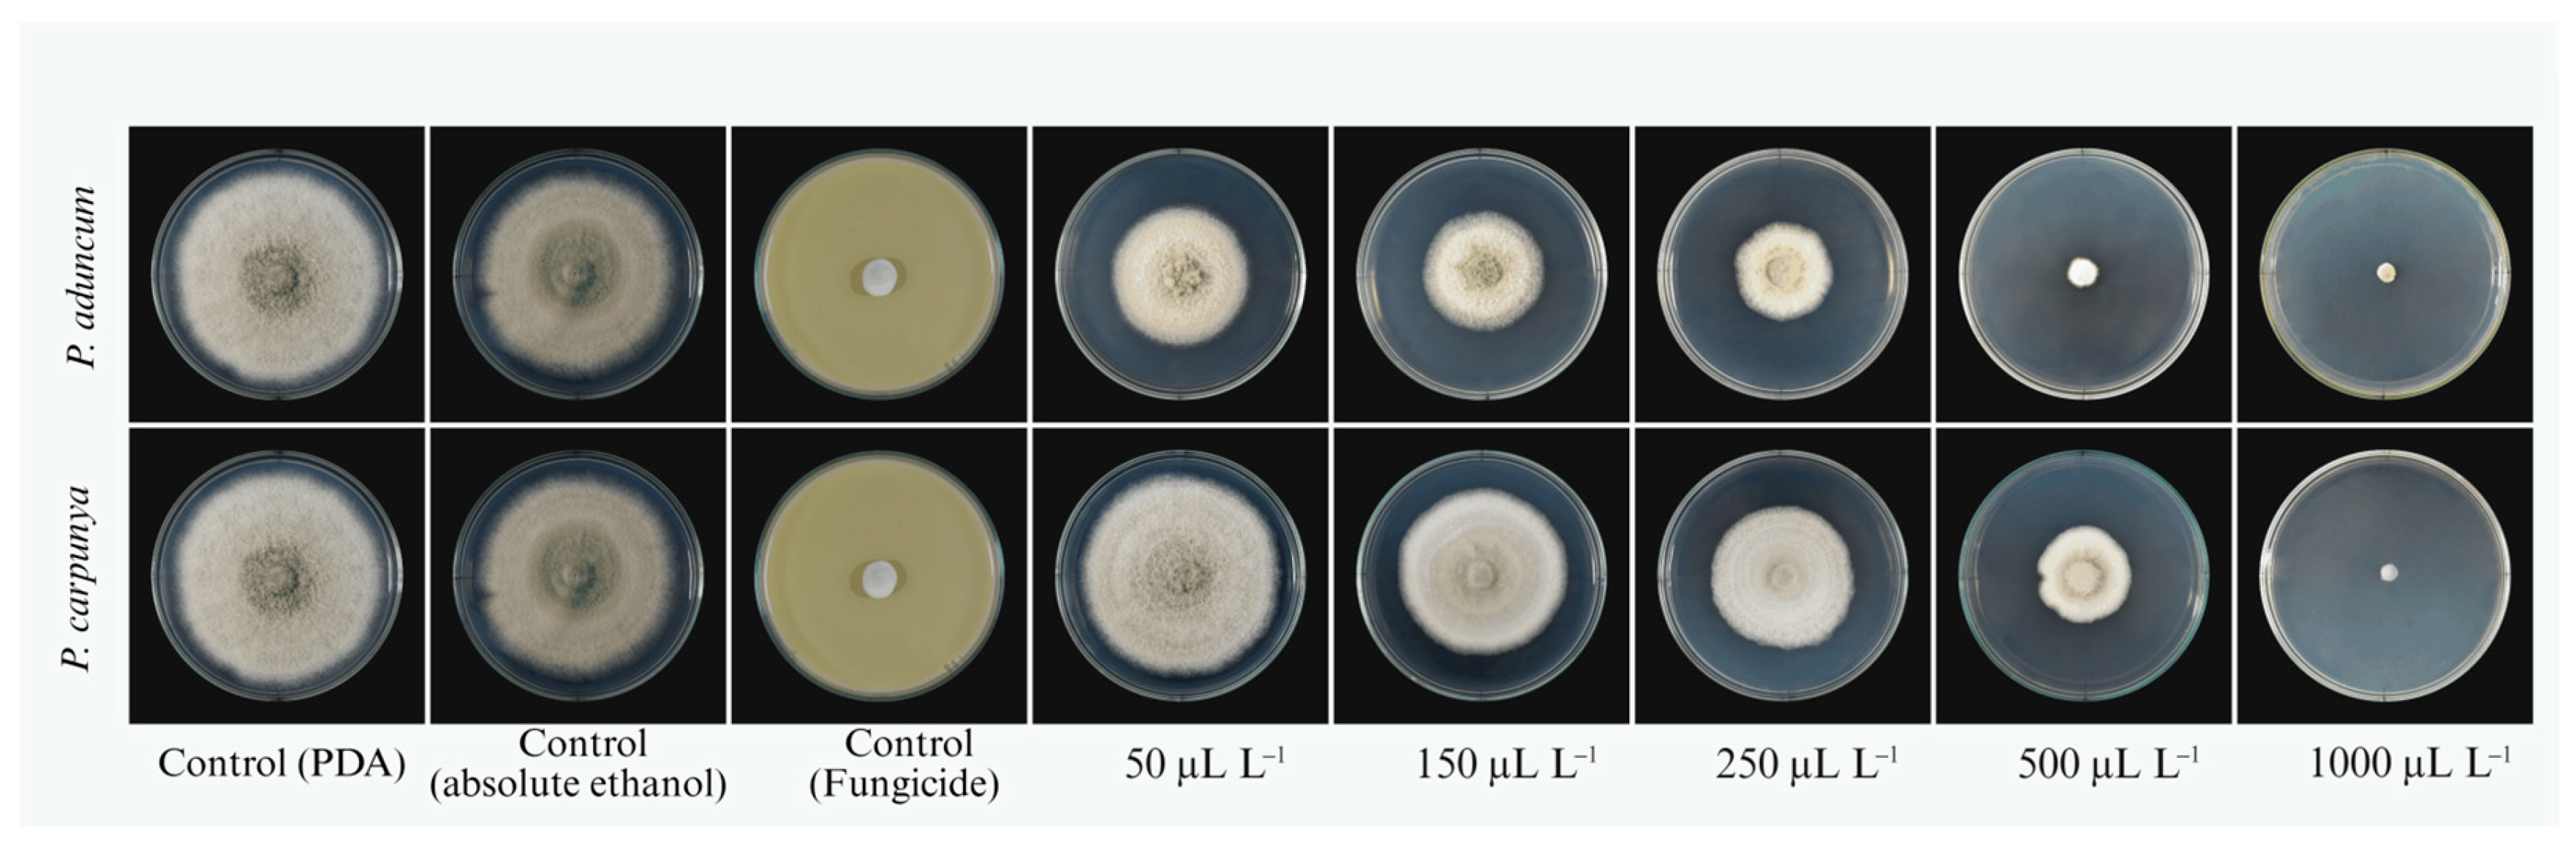
Ijpb 17 00010 g005

Abstract
Anthracnose is one of the most destructive diseases of avocado worldwide; however, foliar infections remain poorly documented in Peru. We investigated the etiology of necrotic leaf lesions observed in avocado plantations in Amazonas and assessed the in vitro antifungal activity of two Piper essential oils (EOs). Incidence was quantified in a 420-tree plot (n = 150 plants). Two representative isolates (MGS03, MGS04) were obtained from symptomatic leaves and characterized by morphology and multilocus sequencing (ITS, CHS-1, ACT, and TUB2). Maximum-likelihood phylogeny within the C. gloeosporioides species complex clustered with C. fructicola. Pathogenicity tests on detached leaves (unwounded inoculation) reproduced field symptoms and fulfilled Koch’s postulates. The antifungal activity of Piper carpunya and P. aduncum EOs (50–1000 µL L−1) was evaluated using poisoned-medium assays, revealing a strong dose-dependent inhibition of mycelial growth. Inhibition reached >89.8% at 500 µL L−1 and ~100% at 1000 µL L−1, with P. aduncum showing slightly higher activity. This study provides the first confirmed record of C. fructicola associated with necrotic leaf lesions in avocado in Peru and demonstrates the promising antifungal potential of Piper EOs as eco-friendly candidates for anthracnose management.
1. Introduction
Avocado (Persea americana Mill.) represents a crop of major economic and social relevance, driven by its high nutritional value and the steadily increasing demand across international markets [1]. Originating from Mexico and Central America, the avocado has been cultivated and consumed for over 8000 years [2]. Over the last two years, global avocado production has surpassed 10 million tons, an increase of over 10% compared with previous years [3,4]. Mexico continues to be the top exporter, followed by Peru, where avocado constitutes a strategic opportunity for local growers. Peru holds a prominent position among the world’s leading exporters, and its production represents a key pillar of the national economy [5]. In this context, in 2024, avocado exports exceeded 500 tons, and although the Amazonas region allocates a relatively small area to this crop, in 2025 it accounted for 27.6% of national production [6].
Despite its importance, the sustainability of avocado cultivation is threatened by several plant diseases. Among them, anthracnose stands out, caused by species of the genus Colletotrichum (Sordariomycetes, Ascomycota), which comprises a broad array of plant pathogens affecting vegetables, legumes, cereals, and numerous tropical and temperate crops worldwide [7]. This genus comprises major plant pathogens that cause significant economic losses across diverse agricultural systems globally [8,9]. In fruit trees and vegetables, Colletotrichum has been widely reported as the causal agent of infections in various plant organs, primarily in fruits [10,11]. Anthracnose, caused by Colletotrichum species, is widely distributed across avocado-producing regions and is extensively reported on both fruits and leaves throughout the crop cycle [12]. To the best of our knowledge, foliar infections of avocado caused by Colletotrichum fructicola have been reported in other avocado-producing countries; however, in Peru, previous studies have mainly documented fruit infections caused by Colletotrichum. Molecularly confirmed reports of foliar infections of avocado caused by C. fructicola have not yet been documented [2].
Colletotrichum comprises filamentous plant-pathogenic fungi with hundreds of species and substantial ecological diversity [13]. In avocado, the most frequently reported species belong to the gloeosporioides complex (C. gloeosporioides, C. siamense; [10,14]) and the boninense complex (C. karstii, C. boninense; [15]), along with members of the acutatum complex (C. nymphaeae; [16,17] and C. fructicola [18]). Regionally, a high diversity associated with avocado has been documented: up to eleven species in Mexico [8,12], and multiple species confirmed as causal agents of anthracnose in Colombia and Brazil, particularly post harvest [14,17,19]. These patterns underscore the need for multilocus identification for reliable diagnosis of Colletotrichum on avocado [10,16].
Anthracnose in avocado is among the most widespread and severe diseases, affecting stems, leaves, flowers, and fruits, especially under high-humidity conditions [13]. Its management largely relies on fungicides; however, repeated applications promote resistance and generate residues that constrain market access [12]. Seeking sustainable alternatives, natural compounds have been evaluated; for instance, oregano essential oil achieved complete in vitro inhibition of C. fructicola in ‘Hass’ avocado via active packaging [20].
Plant-derived essential oils have emerged as promising disease control agents due to their broad-spectrum antifungal activity, biodegradability, and low toxicity [21,22]. Within this context, species of the genus Piper (Piperaceae) have gained increasing attention because of their strong inhibitory effects against phytopathogenic fungi. Piper aduncum and Piper carpunya, native and abundant in the Amazonas department, Peru, are rich in bioactive secondary metabolites such as phenylpropanoids, monoterpenes, and sesquiterpenes, including dillapiole, safrole, and 1,8-cineole, which have been reported to disrupt fungal cell membranes, inhibit spore germination, and suppress mycelial growth [23,24,25].
Essential oil of P. aduncum has demonstrated significant in vitro antifungal activity against several plant pathogens, including Colletotrichum spp., Fusarium spp., and Botrytis cinerea, achieving high levels of mycelial growth inhibition and reduced conidial viability [25,26]. Similarly, P. carpunya essential oil has been shown to inhibit phytopathogenic fungi through alterations in membrane permeability and interference with key metabolic pathways [25,27,28]. The documented antifungal efficacy of these essential oils, together with their natural availability in the Peruvian Amazon and their low environmental impact, supports their selection as sustainable alternatives for the management of avocado anthracnose.
In avocado orchards in the Amazonas department of Peru, we observed leaves with necrotic lesions suggestive of anthracnose. This study aimed to (i) identify the causal agent through morphological and multilocus characterization, (ii) assess its foliar pathogenicity, and (iii) evaluate the in vitro antifungal activity of Piper essential oils. To our knowledge, this is the first confirmed report of Colletotrichum fructicola associated with foliar necrosis in avocado in Peru.
2. Materials and Methods
2.1. Sampling, Incidence, and Isolation
Avocado leaves with necrotic lesions were sampled from the UNTRM Experimental Station in Magdalena, Chachapoyas, Amazonas, Peru (6.400251 S 77.885862 W; 1939 m a.s.l.). Disease incidence was assessed in 150 trees within a 420-tree plot by recording the presence or absence of necrotic leaf lesions per plant, and expressed as the percentage of symptomatic trees. Affected leaves typically showed irregular dark brown spots starting at the margins or apex and expanding along the lamina (Figure 1).
Figure 1.
Field symptoms at the UNTRM Experimental Station, Magdalena, Chachapoyas (Amazonas, Peru). (A,B) Necrotic leaf lesions.
For fungal isolation, symptomatic leaves were washed, surface-disinfected with 3% NaClO for 2 min, rinsed twice in sterile distilled water, and air-dried under sterile conditions. Approximately 1 mm fragments from lesion margins were placed on Potato Dextrose Agar (PDA) and incubated at 25 °C for 7 days [15]. Colonies with morphology consistent with Colletotrichum were transferred to fresh PDA and purified by single-spore isolation. Two representative isolates (MGS03 and MGS04) were selected for morphological and molecular characterization, pathogenicity tests, and in vitro essential oil assays.
2.2. Morphological Identification
Isolates MGS03 and MGS04 were grown on PDA plates and incubated at 25 ± 2 °C. Colony diameter was measured after 7 days along two perpendicular axes, and the radial growth rate (mm day−1) was calculated [29]. Cultural and morphological traits were assessed following the methods of Damm [30]. Micromorphology was examined using the slide culture technique [31]. Small agar blocks from the colony margin were placed on PDA-coated glass slides and incubated in moist chambers at 25 °C until sporulation. Permanent mounts were prepared in lactophenol cotton blue, and conidiophores, conidiogenous cells, conidia, and appressoria were observed with an Olympus microscope equipped with a DP74 digital camera (Olympus, Tokyo, Japan). For each isolate, at least 50 measurements per structure were taken to determine size ranges and mean ± standard deviation. Morphological features were compared with published descriptions of species within the Colletotrichum gloeosporioides complex [30].
2.3. Molecular Analysis and Phylogeny
Total DNA was extracted using the Wizard® Genomic DNA Purification Kit (Promega, WI, USA) according to the manufacturer’s instructions. DNA concentration was quantified using a BioSpectrometer® basic (Eppendorf, NJ, USA) and subsequently diluted to 0.5 ng/μL for PCR reactions. Four informative regions were amplified: the internal transcribed spacer region (ITS) (ITS1, 5.8S, and ITS2), chitin synthase (CHS-1), partial actin (ACT), β-tubulin (TUB2). The primer pair ITS-1F/ITS4R was used for amplification [32] CHS-79F/CHS-345R, ACT-512F/ACT-783R [33], BT2a/BT2b [34]. The amplified PCR products were purified and sequenced using the Sanger method. Sequences were edited with Sequencher version 5.4.6 (Gene Codes, Ann Arbor, MI, USA) [35]. Edited sequences were aligned with MUSCLE [36] implemented in MEGA 11.0 [37]. Subsequently, they were concatenated with Seaview [38]. The phylogenetic analysis by maximum likelihood was performed on the CIPRES Science Gateway platform [39]. The resulting tree was midpoint-rooted and edited using iTools version 4.5.1.9. [40]. GenBank accession numbers of the sequences used in the phylogenetic analysis are listed in Table 1.
Table 1.
GenBank accession numbers of DNA sequences of Colletotrichum gloeosporioides species complex included in phylogenetic study.
2.4. Pathogenicity Tests
Pathogenicity tests were performed on young avocado (Persea americana) leaves under controlled laboratory conditions. Leaves were surface-sterilized following the protocol described by [30] and placed in moist chambers. Two inoculation methods were used. In the first, mycelial disks (5 mm diameter) from actively growing cultures were placed on slightly wounded leaf tissues. In the second, a conidial suspension (1 × 106 conidia mL−1) was applied to unwounded leaf surfaces to simulate natural infection. Sterile distilled water was used as a negative control. Each isolate was tested with six replicates per method, including controls. Inoculated leaves were incubated at 25 °C under high humidity and monitored daily for symptom development. To fulfill Koch’s postulates, the pathogen was reisolated from symptomatic tissues and cultured on potato dextrose agar (PDA). Conidial masses were documented using a stereomicroscope (SMZ18, Nikon, Tokyo, Japan), and detailed observations were performed by scanning electron microscopy (SEM; ZEISS Smart SEM v7.05, Oberkochen, Germany) after drying infected tissues in silica gel for 24 h.
2.5. In Vitro Inhibition Test with Essential Oils
The antifungal activity of essential oils from Piper aduncum and Piper carpunya, provided by the Plant Health Research Laboratory, was evaluated against C. fructicola. The assay was conducted using the poisoned food technique [41]. Five different concentrations of both oils (50, 150, 250, 500, and 1000 µL L−1) were prepared, dissolved in absolute ethyl alcohol (1:2 v/v), and incorporated into molten PDA (Potato Dextrose Agar) cooled to 45 °C. Twenty milliliters (20 mL) of the solution from each concentration were added to sterile Petri dishes and allowed to solidify. Subsequently, 6 mm diameter agar disks containing seven-day-old C. fructicola mycelia from the active growth zones were cut and placed in the center of each plate. The assays included a control treatment (without oils). Additionally, two reference controls were included: (i) an absolute ethanol control (EtOH, ≥99.8%) at the same solvent proportion used for essential oil dilution, and (ii) a commercial fungicide control at the recommended dose. Five plates per treatment were used and incubated at 24 °C. Colony diameters were measured with a digital vernier caliper every 48 h for ten days. The percentage of Mycelial Growth Inhibition (MGI) was calculated as follows:
where Dc is the mean colony diameter in the control, and Dt is the mean colony diameter in the essential oil treatment.
2.6. Statistical Analysis
The relationship between essential oil concentration and mycelial growth inhibition (MGI) was modeled using a nonlinear log–logistic regression implemented in the drc package in R to estimate ED50 and ED90 values. The model was fitted as follows:
where b is the slope of the dose–response curve and ED50 represents the concentration producing 50% inhibition. Lower and upper limits were fixed at 0 and 100%, respectively.
3. Results
3.1. Incidence
In the UNTRM avocado plot, necrotic leaf lesions caused by Colletotrichum fructicola were detected in 60% of the 150 evaluated trees. Affected leaves developed irregular dark brown to black necrotic lesions that typically originated at the margins or apex and expanded toward the lamina center, often coalescing into larger necrotic areas (Figure 1). In advanced stages, severe necrosis led to partial defoliation. Under high humidity, pink to orange conidial masses characteristic of Colletotrichum were observed on the lesion surface.
3.2. Morphological and Molecular Characterization
In this study, two isolates obtained from symptomatic leaves (MGS03 and MGS04) displayed cultural and morphological traits consistent with the C. fructicola species complex as described by Weir et al. [10].
Colletotrichum fructicola Prihastuti L. Cai & K.D. Hyde, Fungal Diversity 39: 158. 2009
Macroscopic characteristics (Figure 2A): After seven days on PDA at 25 ± 2 °C, C. fructicola showed an average growth rate of 29.6 ± 0.19 mm/day, with dense, velvety mycelium and progressively dark pigmentation. The colonies displayed concentric zones ranging from gray to black, with the reverse showing characteristic brown to black pigmentation. Microscopic characteristics (Figure 2B–D): Conidiophores were hyaline, septate, and cylindrical. Conidia were hyaline, smooth, and cylindrical to clavate in shape, measuring on average 16.00 × 4.04 µm (range: 15.08–17.08 × 3.63–4.39 µm; n = 50). Appressoria were brown, solitary or grouped, elliptic to lobed in outline, and developed from vegetative hyphae.
Figure 2.
C. fructicola. (A) Upper and lower views of colonies grown on potato dextrose agar (PDA) and incubated at 28 °C for seven days; (B) conidiophores (red arrow); (C) conidia; (D) appressoria (red arrow). Scale bars: 1 mm (A), 20 µm (B,D), 50 µm (C).
Molecular analysis: From the two isolates obtained, C. fructicola MGS03 and MGS04, sequences were generated for each. Alignment of the ITS, CHS-1, ACT and TUB2 markers produced a dataset comprising 1863 characters, including gaps: ITS (1–592), CHS-1 (593–865), ACT (866–1131), and TUB2 (1132–1863). Phylogenetic analysis was conducted under the Transitional model with equal base frequencies and a discrete Gamma model to account for rate heterogeneity, as estimated by jModelTest. The phylogenetic analysis based on the concatenated multilocus dataset [42] revealed that isolates MGS03 and MGS04 clustered with the type strain Colletotrichum fructicola ICMP 18581, with 93% bootstrap support (Figure 3). Notes: C. fructicola was initially reported in coffee berries as an endophyte and pathogen in Thailand [43] and later as an endophyte in cocoa leaves (Theobroma cacao), corresponding to the ex-holotype crop of C. ignotum (syn. C. fructicola; CBS 125397 = ICMP 18646) [44,45]. In 2022, the species was isolated in China from avocado fruits (Persea americana cv. Hass) with symptoms of anthracnose, exported from Peru [46]. In 2024, C. fructicola was isolated from anthracnose cocoa leaves in the Amazonas region, Peru [47]. In this study, C. fructicola is reported for the first time causing foliar lesions in avocado in Peru.
Figure 3.
Phylogenetic analysis of isolates belonging to the C. fructicola species complex included isolates obtained in this study. A concatenated dataset of (ITS, ACT, CHS-1, and TUB2) was used to construct the phylogeny. Isolates obtained in this study are shown in bold. The yellow shading indicates the C. fructicola clade. Asterisks (*) denote type or reference sequences.
3.3. Pathogenicity Tests
Pathogenicity assays on detached avocado leaves confirmed that isolates MGS03 and MGS04 reproduced the disease symptoms observed in the field. Three days after inoculation, inoculated leaves developed typical anthracnose lesions, characterized by dark necrotic spots expanding from the inoculation point to the mycelial disk (Figure 4B) and conidial suspension (Figure 4C). No symptoms were recorded in non-inoculated control leaves (Figure 4A). Conidiomata and conidial masses formed on inoculated tissues (Figure 4D), and fungal colonization was detailed by SEM (Figure 4E). The pathogen was successfully reisolated from symptomatic tissues and identified as C. fructicola based on its cultural and morphological features, thereby fulfilling Koch’s postulates.
Figure 4.
Pathogenicity test of C. fructicola. (A) Non-inoculated leaf; (B) leaves inoculated with mycelial disks; (C) leaves inoculated with conidial suspension; (D) presence of reproductive structures (conidial masses); (E) conidial masses observed by SEM, Scale bar = 30 μm.
3.4. Inhibition Test
The in vitro inhibition assay revealed that both P. aduncum and P. carpunya essential oils (EOs) significantly inhibited the mycelial growth of C. fructicola in a clear dose-dependent manner (Table 2; Figure 5). At lower concentrations (50–150 µL L−1), inhibition was moderate and remained below 30% for both EOs. At 250 µL L−1, P. aduncum exhibited a markedly stronger inhibitory effect (58.2%) than P. carpunya (23.9%). A sharp increase in antifungal activity was observed from 500 µL L−1 onward, with P. aduncum achieving inhibition values close to 90%, while P. carpunya reached approximately 57%. At the highest concentration (1000 µL L−1), both essential oils completely inhibited fungal growth, reaching 100% inhibition. Overall, P. aduncum consistently showed higher antifungal potency than P. carpunya across all tested concentrations.
Table 2.
Mycelial growth and inhibition (%) of C. fructicola under different concentrations of essential oils in the in vitro inhibition assay.
Figure 5.
In vitro inhibition testing of C. fructicola. Marked inhibition of mycelial growth is observed in the presence of essential oils compared with the controls.
This dose-dependent trend was further supported by dose–response modeling, which showed lower effective dose values for P. aduncum (ED50 = 209.37 ± 13.95 µL L−1; ED90 = 604.40 ± 101.00 µL L−1; R2 = 0.93) compared with P. carpunya (ED50 = 385.60 ± 24.22 µL L−1; ED90 = 1114.18 ± 150.12 µL L−1; R2 = 0.92), confirming the higher antifungal efficacy of P. aduncum against C. fructicola (Figure 6).
Figure 6.
Effects of different concentrations of essential oils from Piper aduncum (A) and P. carpunya (B) on mycelial growth of Colletotrichum fructicola. Dose–response curves fitted using logistic model.
4. Discussion
In this study, Colletotrichum fructicola was confirmed as the causal agent of necrotic leaf lesions in avocado in the Amazonas region of Peru. The symptomatology observed in the field—irregular dark brown to black spots originating at the leaf margins, frequently coalescing into larger necrotic patches—is consistent with descriptions of foliar anthracnose in avocado and other tropical hosts [13,36]. The recorded incidence (60%) reflects a high disease pressure under local environmental conditions, particularly the region’s high humidity, which favors sporulation, secondary infections, and the rapid expansion of necrotic lesions [37]. High foliar damage of this type is known to reduce photosynthetically active leaf area and compromise plant vigor and productivity [38,39].
The high disease incidence recorded in this study (60%) indicates intense disease pressure and can be largely explained by the prevailing agroclimatic conditions of the Amazonas region. This area is characterized by persistently high relative humidity, frequent rainfall events, and moderate temperatures, all of which are known to favor Colletotrichum infection processes, including conidial germination, appressorium formation, and secondary dispersal [11,16]. Prolonged leaf wetness periods enhance the establishment and expansion of necrotic lesions, accelerating epidemic development in perennial crops such as avocado [48]. Severe foliar damage of this nature has been shown to significantly reduce the photosynthetically active leaf area, negatively affecting carbon assimilation, plant vigor, and ultimately yield potential [49,50].
Previous studies in Peru have primarily reported anthracnose in avocado fruits rather than leaves, with C. siamense and C. fructicola identified as predominant causal agents in postharvest and field infections [51]. These studies documented lower disease incidence or focused on fruit symptomatology, reflecting differences in host tissue susceptibility, environmental exposure, and management practices. In contrast, the present work demonstrates that C. fructicola is capable of causing severe foliar infections under the humid conditions of the Amazonas region, suggesting a broader epidemiological role for this species in Peruvian avocado systems.
Comparatively, C. siamense has been reported as highly aggressive in fruit infections under warm and humid conditions, while C. fructicola has been associated with both fruit and leaf symptoms in other avocado-producing countries [10,52]. However, molecularly confirmed reports of foliar anthracnose caused by C. fructicola in avocado had not been previously documented in Peru. Therefore, this study represents the first molecular evidence of C. fructicola infecting avocado leaves in the country, expanding current knowledge on the diversity, tissue specificity, and epidemiological relevance of Colletotrichum species affecting avocado. Overall, the high incidence observed highlights the need to consider foliar anthracnose as an emerging constraint in humid avocado-growing regions of Peru. Integrated disease management strategies that incorporate climatic risk, early detection, and targeted control measures are essential to mitigate the impact of Colletotrichum-induced foliar damage and sustain avocado productivity under increasingly favorable conditions for pathogen development.
The morphological and cultural traits of isolates MGS03 and MGS04 matched those described for members of the C. gloeosporioides species complex, characterized by dense, dark colonies with concentric zonation and cylindrical hyaline conidia [10,11]. Multilocus phylogenetic analysis (ITS, CHS-1, ACT, and TUB2) placed both isolates in a well-supported clade with the type strain Colletotrichum fructicola ICMP 18581, confirming their taxonomic identity. This multilocus approach is essential for species delimitation within Colletotrichum, a genus known for its cryptic diversity and morphological overlap among species complexes [36,44]. Comparable diversity patterns have been reported in avocado-producing countries such as Mexico, Brazil, Israel, and Colombia, where several phylogenetically distinct Colletotrichum species co-occur and may infect different plant organs [8,12,14,17,19]. The present work expands the geographical distribution of C. fructicola affecting avocado leaves and constitutes the first confirmed report for Peru.
Pathogenicity tests reproduced the characteristic necrotic lesions within three days post inoculation, fulfilling Koch’s postulates and confirming the foliar pathogenicity of the isolates. Similar rapid lesion development has been documented in pathogenicity assays of Colletotrichum spp. on avocado and mango leaves [37,45]. The rapid onset of symptoms observed here suggests a high virulence potential, particularly under conditions favorable to fungal growth. Previous studies indicate that species within the C. gloeosporioides complex exhibit considerable variability in aggressiveness and tissue specificity [42,43], which may explain the severe foliar deterioration observed in the field.
The essential oils of P. aduncum and P. carpunya displayed strong, dose-dependent antifungal activity against C. fructicola, with inhibition reaching 89.8% at 500 µL L−1 for P. aduncum and 56.6% for P. carpunya, and both oils fully inhibited mycelial growth (100%) at 1000 µL L−1. These results agree with previous studies reporting potent activity of Piper essential oils against phytopathogenic fungi, including Moniliophthora roreri, Alternaria alternata, and other Colletotrichum species [46,47]. Their antifungal mechanism involves phenylpropanoids and terpenoids—such as dillapiole, safrole, eugenol, and β-caryophyllene—which disrupt membrane integrity, increase permeability, and interfere with essential enzymatic processes [48]. The high sensitivity of C. fructicola to Piper metabolites underscores the potential of these oils as natural antifungal agents, particularly in regions where synthetic fungicide use is restricted or resistance has been reported.
Overall, this study provides new evidence of the epidemiological relevance of C. fructicola as a foliar pathogen in Peruvian avocado orchards and demonstrates the strong inhibitory effect of two Piper essential oils against this pathogen. These findings highlight the importance of integrating molecular diagnostics with sustainable disease management strategies and position the Piper genus as a promising source of bioactive compounds for anthracnose control in tropical agriculture. Future studies should evaluate the efficacy of Piper essential oils under greenhouse and field conditions, as well as their compatibility with integrated disease management programs.
5. Conclusions
This study reports Colletotrichum fructicola as the causal agent of necrotic leaf lesions in avocado in the Amazonas department, Peru. Additionally, the essential oils of P. aduncum and P. carpunya exhibited potent mycelial inhibition (100% at 1000 µL L−1), underscoring their potential as effective natural alternatives to synthetic fungicides. Together, these results highlight the Piper genus as a promising source of sustainable bioactive compounds for the integrated management of avocado anthracnose.
Author Contributions
Conceptualization, M.G.-S., J.R.-V. and A.F.H.-P.; methodology, A.F.H.-P., E.C.-C. and E.G.-Z.; validation, A.F.H.-P.; formal analysis, M.G.-S., J.R.-V. and E.G.-Z.; investigation, M.O.-C.; data curation, E.G.-Z. and E.C.-C.; writing—original draft preparation, M.G.-S., J.R.-V., E.C.-C. and E.G.-Z.; writing—review and editing, M.O.-C. and A.F.H.-P.; visualization, E.C.-C.; supervision, M.O.-C. All authors have read and agreed to the published version of the manuscript.
Funding
This work has been financed by the CUI Project No. 2590699: Mejoramiento del Servicio de Promoción de la Ciencia, Tecnología e Innovación Tecnológica en Centro de Investigación en Fruticultura “CIF” de la UNTRM—Distrito de Magdalena de la Provincia de Chachapoyas del Departamento de Amazonas “CIF” of the UNTRM—Magdalena District, Chachapoyas Province of the Amazonas Department. The vice chancellor’s office of research at the National University Toribio Rodríguez of Mendoza of Amazonas funded the APC.
Data Availability Statement
The datasets generated in this study are available in the NCBI repository (https://www.ncbi.nlm.nih.gov/, accessed on 2 February 2026), with accession numbers provided in the article.
Acknowledgments
The authors would like to thank all members of the Plant Health Research Laboratory for their help during the conduct of this study.
Conflicts of Interest
The authors declare no conflicts of interest.
References
- Coyotl-Pérez, W.A.; Rubio-Rosas, E.; Morales-Rabanales, Q.N.; Ramírez-García, S.A.; Pacheco-Hernández, Y.; Pérez-España, V.H.; Romero-Arenas, O.; Villa-Ruano, N. Improving the Shelf Life of Avocado Fruit against Clonostachys rosea with Chitosan Hybrid Films Containing Thyme Essential Oil. Polymers 2022, 14, 2050. [Google Scholar] [CrossRef]
- Bustamante, M.I.; Osorio-Navarro, C.; Fernández, Y.; Bourret, T.B.; Zamorano, A.; Henríquez-Sáez, J.L. First Record of Colletotrichum anthrisci Causing Anthracnose on Avocado Fruits in Chile. Pathogens 2022, 11, 1204. [Google Scholar] [CrossRef] [PubMed]
- OECD-FAO. OECD-FAO Agricultural Outlook 2025–2034; OECD Publishing: Paris, France, 2025; Available online: https://www.oecd.org/en/publications/oecd-fao-agricultural-outlook-2025-2034_601276cd-en.html (accessed on 2 January 2026).
- Collantes-Barturen, F.J.A.; Morán-Santamaría, R.O. Impact of Avocado Exports on Peruvian Economic Growth. Sustainability 2025, 17, 4460. [Google Scholar] [CrossRef]
- Flores-Izquierdo, M.A.; Espinoza-Villanueva, L.E. Situación actual y perspectivas de la producción de palta (Persea americana) peruana en el contexto del comercio internacional. Ing. Ind. 2023, 45, 157–173. [Google Scholar] [CrossRef]
- Instituto Nacional de Estadística e Informática (INEI). Producción de Palta Creció en 112.9% Durante Setiembre de 2025 y Tres Departamentos Concentraron el 83.7% del Total Nacional; INEI: Lima, Peru, 2025; Available online: https://www.gob.pe/institucion/inei/noticias/1297239-produccion-de-palta-crecio-en-setiembre-de-2025 (accessed on 1 January 2026).
- Guevara-Suarez, M.; Cárdenas, M.; Jiménez, P.; Afanador-Kafuri, L.; Restrepo, S. Colletotrichum Species Complexes Associated with Crops in Northern South America: A Review. Agronomy 2022, 12, 548. [Google Scholar] [CrossRef]
- Trinidad-Ángel, E.; Ascencio-Valle, F.d.J.; Ulloa, O.A.; Ramírez-Ramírez, O.C.; Ragazzo-Sánchez, J.A.; Calderón-Santoyo, M.; Rosales, P.U.B. Identification and characterization of Colletotrichum spp. causing anthracnose in avocado Nayarit, Mexico. Rev. Mex. Cienc. Agrícolas 2017, 8, 3953–3964. [Google Scholar] [CrossRef]
- Armand, A.; Jayawardena, R.S. Morphomolecular identification and pathogenicity of Colletotrichum species associated with avocado anthracnose in northern Thailand. Plant Pathol. 2024, 73, 186–197. [Google Scholar] [CrossRef]
- Wang, W.; de Silva, D.D.; Moslemi, A.; Edwards, J.; Ades, P.K.; Crous, P.W.; Taylor, P.W.J. Colletotrichum species causing anthracnose of citrus in Australia. J. Fungi 2021, 7, 47. [Google Scholar] [CrossRef]
- Cannon, P.F.; Damm, U.; Johnston, P.R.; Weir, B.S. Colletotrichum—Current status and future directions. Stud. Mycol. 2012, 73, 181–213. [Google Scholar] [CrossRef]
- Fuentes-Aragón, D.; Silva-Rojas, H.V.; Guarnaccia, V.; Mora-Aguilera, J.A.; Aranda-Ocampo, S.; Bautista-Martínez, N.; Téliz‐Ortíz, D. Colletotrichum species causing anthracnose on avocado fruit in Mexico: Current status. Plant Pathol. 2020, 69, 1513–1528. [Google Scholar] [CrossRef]
- Uysal, A.; Kurt, Ş. First report of fruit and leaf anthracnose caused by Colletotrichum karstii on avocado in Turkey. Crop Prot. 2020, 133, 105145. [Google Scholar] [CrossRef]
- Soares, M.G.O.; Lves, E.; Silveira, A.L.; Pereira, F.D.; Guimarães, S.S.C. Colletotrichum siamense is the main aetiological agent of anthracnose of avocado in south-eastern Brazil. Plant Pathol. 2021, 70, 154–166. [Google Scholar] [CrossRef]
- Wu, C.-J.; Lin, M.-C.; Ni, H.-F. Colletotrichum species causing anthracnose disease on avocado fruit in Taiwan. Eur. J. Plant Pathol. 2023, 165, 629–647. [Google Scholar] [CrossRef]
- Damm, U.; Cannon, P.F.; Woudenberg, J.H.C.; Crous, P.W. The Colletotrichum acutatum species complex. Stud. Mycol. 2012, 73, 37–113. [Google Scholar] [CrossRef]
- de Oliveira, V.C.; da Silva, H.A.O.; Lourenço, M.T.; Armond, M.L.d.P.; Abreu, L.M.; Mendes, F.Q.; de Oliveira, E.B.; Vieira, É.N.R. Isolation and Identification of Pathogenic Fungi (Colletotrichum nymphaeae and C. siamense) From Avocado and Sensitivity to Essential Oils from Pelargonium graveolens or Cordia verbenacea. Plant Pathol. 2025, 75, e70081. [Google Scholar] [CrossRef]
- Ma, A.; Xu, Y.; Feng, H.; Du, Y.; Liu, H.; Yang, S.; Chen, J.; Hao, X. Identification of Avocado Fruit Disease Caused by Diaporthe phaseolorum and Colletotrichum fructicola in China. J. Fungi 2025, 11, 547. [Google Scholar] [CrossRef]
- Ángel-García, C.; Rodríguez-Arevalo, K.A.; Riaño, N.M.; Martínez-Caballero, L.N.; Ceballos-Aguirre, G.; Laverde, A.J.; Martínez, M.F. Molecular Identification and Fungal Diversity Associated with Diseases in Hass Avocado Fruit Grown in Cauca, Colombia. Pathogens 2023, 12, 1418. [Google Scholar] [CrossRef]
- Colín-Chávez, C.; Virgen-Ortiz, J.J.; Martínez-Téllez, M.Á.; Avelino-Ramírez, C.; Gallegos-Santoyo, N.L.; Miranda-Ackerman, M.A. Control of anthracnose (Colletotrichum gloeosporioides) growth in “Hass” avocado fruit using sachets filled with oregano oil-starch-capsules. Future Foods 2024, 10, 100394. [Google Scholar] [CrossRef]
- Burt, S. Essential oils: Their antibacterial properties and potential applications in foods—A review. Int. J. Food Microbiol. 2004, 94, 223–253. [Google Scholar] [CrossRef]
- Jhalegar, M.J.; Sharma, R.R.; Singh, D. In vitro and in vivo activity of essential oils against major postharvest pathogens of Kinnow (Citrus nobilis × C. deliciosa) mandarin. J. Food Sci. Technol. 2015, 52, 2229–2237. [Google Scholar] [CrossRef]
- Debonsi Navickiene, H.M.; de Morandim, A.A.; Alécio, A.C.; Regasin, L.O.; Cristina Bergamo, D.B.; Telascrea, M.; Cavalheiro, A.J.; Lopes, M.N.; Bolzani, V.d.S.; Furlan, M.; et al. Composition and antifungal activity of essential oils from Piper aduncum, Piper arboreum and Piper tuberculatum. Quim. Nova 2006, 29, 467–470.v. [Google Scholar] [CrossRef]
- Pereira Filho, A.A.; do Vale, V.F.; de Oliveira Monteiro, C.M.; Barrozo, M.M.; Stanton, M.A.; Yamaguchi, L.F.; Kato, M.J.; Araújo, R.N. Effects of Piper aduncum (Piperales: Piperaceae) Essential Oil and Its Main Component Dillapiole on Detoxifying Enzymes and Acetylcholinesterase Activity of Amblyomma sculptum (Acari: Ixodidae). Int. J. Mol. Sci. 2024, 25, 5420. [Google Scholar] [CrossRef] [PubMed]
- Ballesteros, J.L.; Tacchini, M.; Spagnoletti, A.; Grandini, A.; Paganetto, G.; Neri, L.M.; Marengo, A.; Angiolella, L.; Guerrini, A.; Sacchetti, G. Rediscovering medicinal Amazonian aromatic plants: Piper carpunya (Piperaceae) essential oil as paradigmatic study. Evid.-Based Complement. Altern. Med. 2019, 2019, 6194640. [Google Scholar] [CrossRef] [PubMed]
- da Silva, J.K.R.; Pinto, L.C.; Burbano, R.M.R.; Montenegro, R.C.; Guimarães, E.F.; Andrade, E.H.A.; Maia, J.G.S. Essential oils of Amazon Piper species and their cytotoxic, antifungal, antioxidant and anti-cholinesterase activities. Ind. Crops. Prod. 2014, 58, 55–60. [Google Scholar] [CrossRef]
- Vargas, L.; Velasco-Negueruela, A.; Pérez-Alonso, M.J.; Palá-Paúl, J.; Vallejo, M.C.G. Essential Oil Composition of the Leaves and Spikes of Piper carpunya Ruíz et Pavón (Piperaceae) from Peru. J. Essent. Oil Res. 2004, 16, 122–123. [Google Scholar] [CrossRef]
- Ruiz-Vásquez, L.; Mesia, L.R.; Ceferino, H.D.C.; Mesia, W.R.; Andrés, M.F.; Díaz, C.E.; Gonzalez-Coloma, A. Antifungal and Herbicidal Potential of Piper Essential Oils from the Peruvian Amazonia. Plants 2022, 11, 1793. [Google Scholar] [CrossRef]
- Zhang, L.; Zhao, L.; Liang, C.; Yu, L.; Zhang, Y. Colletotrichum species (Glomerellales, Glomerellaceae) causing walnut anthracnose in China. MycoKeys 2024, 108, 95–113. [Google Scholar] [CrossRef]
- Zhang, L.; Yin, Y.Q.; Zhao, L.L.; Xie, Y.Q.; Han, J.; Zhang, Y. Two new species of Colletotrichum (Glomerellaceae, Glomerellales) causing walnut anthracnose in Beijing. MycoKeys 2023, 99, 131–152. [Google Scholar] [CrossRef]
- Nugent, L.K.; Sangvichen, E.; Sihanonth, P.; Ruchikachorn, N.; Whalley, A.J. A revised method for the observation of conidiogenous structures in fungi. Mycologist 2006, 20, 111–114. [Google Scholar] [CrossRef]
- Gardes, M.; Bruns, T.D. ITS primers with enhanced specificity for basidiomycetes—Application to the identification of mycorrhizae and rusts. Mol. Ecol. 1993, 2, 113–118. [Google Scholar] [CrossRef]
- Carbone, I.; Kohn, L.M. A method for designing primer sets for speciation studies in filamentous ascomycetes. Mycologia 1999, 91, 553–556. [Google Scholar] [CrossRef]
- Panaccione, D.G.; Hanau, R.M. Characterization of two divergent β-tubulin genes from Colletotrichum graminicola. Gene 1990, 86, 163–170. [Google Scholar] [CrossRef] [PubMed]
- Huaman-Pilco, J.; Huaman-Pilco, Á.F.; Hernández-Diaz, E.; Oliva-Cruz, S.M.; Díaz-Valderrama, J.R. Dieback and pod rot caused by Lasiodiplodia theobromae and L. iraniensis in native accessions of cacao (Theobroma cacao) from Amazonas, Peru. Indian Phytopathol. 2024, 77, 693–703. [Google Scholar] [CrossRef]
- Edgar, R.C. MUSCLE: Multiple sequence alignment with high accuracy and high throughput. Nucleic Acids Res. 2004, 32, 1792–1797. [Google Scholar] [CrossRef]
- Kumar, S.; Stecher, G.; Li, M.; Knyaz, C.; Tamura, K. MEGA X: Molecular evolutionary genetics analysis across computing platforms. Mol. Biol. Evol. 2018, 35, 1547–1549. [Google Scholar] [CrossRef]
- Miller, M.A.; Pfeiffer, W.; Schwartz, T. Creating the CIPRES Science Gateway for inference of large phylogenetic trees. In Proceedings of the 2010 Gateway Computing Environments Workshop GCE, New Orleans, LA, USA, 14 November 2010. [Google Scholar] [CrossRef]
- Gouy, M.; Guindon, S.; Gascuel, O. Sea view version 4: A multiplatform graphical user interface for sequence alignment and phylogenetic tree building. Mol. Biol. Evol. 2010, 27, 221–224. [Google Scholar] [CrossRef]
- Rambaut, A. FigTree, Version 1.4.4; Tree Bioinformatics Group: Edinburgh, UK, 2018; Available online: https://tree.bio.ed.ac.uk/software/figtree/ (accessed on 10 June 2025).
- Kahramanoğlu, İ.; Panfilova, O.; Kesimci, T.G.; Bozhüyük, A.U.; Gürbüz, R.; Alptekin, H. Control of Postharvest Gray Mold at Strawberry Fruits Caused by Botrytis cinerea and Improving Fruit Storability through Origanum onites L. and Ziziphora clinopodioides L. Volatile Essential Oils. Agronomy 2022, 12, 389. [Google Scholar] [CrossRef]
- Sharma, G.; Maymon, M.; Freeman, S. Epidemiology, pathology and identification of Colletotrichum including a novel species associated with avocado (Persea americana) anthracnose in Israel. Sci. Rep. 2017, 7, 15839. [Google Scholar] [CrossRef]
- Prihastuti, H.; Cai, L.; Chen, H.; Mckenzie, E.H.C.; Hyde, K.D. Characterization of Colletotrichum species associated with coffee berries in northern Thailand. Fungal Divers. 2009, 39, 89–109. [Google Scholar]
- Rojas, E.I.; Rehner, S.A.; Samuels, G.J.; Van Bael, S.A.; Herre, E.A.; Cannon, P.; Chen, R.; Pang, J.; Wang, R.; Zhang, Y.; et al. Colletotrichum gloeosporioides s.l. associated with Theobroma cacao and other plants in Panamá: Multilocus phylogenies distinguish host-associated pathogens from asymptomatic endophytes. Mycologia 2010, 102, 1318–1338. [Google Scholar] [CrossRef]
- Weir, B.S.; Johnston, P.R.; Damm, U. The Colletotrichum gloeosporioides species complex. Stud. Mycol. 2012, 73, 115–180. [Google Scholar] [CrossRef]
- Li, S.; Liu, Z.; Zhang, W. First Report of Anthracnose Disease on Avocado (Persea americana) Caused by Colletotrichum fructicola in China. Plant Dis. 2022, 106, 2529. [Google Scholar] [CrossRef]
- Huaman-Pilco, A.F.; Huaman-Pilco, J.; Gaslac-Zumaeta, E.; Fernandez-Rodriguez, Y.; Hernández-Díaz, E.; Rafael-Aguilar, V.; Ramos-Carrasco, T.A.; Torres-delaCruz, M.; Zamorano, A.; Díaz-Valderrama, J.R. Morphology and phylogeny of three Colletotrichum species causing cacao anthracnose in Peru. J. Plant Pathol. 2026, in press. [Google Scholar] [CrossRef]
- Agrios-Rojas, G. Plant Pathology, 5th ed.; Elsevier Academic Press: Amsterdam, The Netherlands, 2025; pp. 26–27. [Google Scholar]
- Silva, H.V.; Ávila-Quezada, G.D. Phylogenetic and morphological identification of Colletotrichum boninense: A novel causal agent of anthracnose in avocado. Plant Pathol. 2011, 60, 899–908. [Google Scholar] [CrossRef]
- De Silva, D.D.; Ades, P.K.; Taylor, P.W.J. Pathogenicity of Colletotrichum species causing anthracnose of Capsicum in Asia. Plant Pathol. 2021, 70, 875–884. [Google Scholar] [CrossRef]
- Morales-García, J.L.; López-Cornejo, C.I.; Pedraza-Santos, M.E.; Chávez-Bárcenas, A.T.; Esquivel-Miguel, E.; García-Morales, S.; Pineda-Guillermo, S. Morpho-molecular identification of the causal agent of avocado scab in Michoacán. Rev. Mex. Fitopatol. 2023, 41, 182–202. [Google Scholar] [CrossRef]
- Chen, X.; Jiang, Z.; He, P.; Tang, X.; Song, H.; Zhang, T.; Wei, Z.; Dong, T.; Zheng, S.; Tu, X.; et al. Effects of Anthracnose on the Structure and Diversity of Endophytic Microbial Communities in Postharvest Avocado Fruits. Agronomy 2024, 14, 2487. [Google Scholar] [CrossRef]
Disclaimer/Publisher’s Note: The statements, opinions and data contained in all publications are solely those of the individual author(s) and contributor(s) and not of MDPI and/or the editor(s). MDPI and/or the editor(s) disclaim responsibility for any injury to people or property resulting from any ideas, methods, instructions or products referred to in the content. |
© 2026 by the authors. Licensee MDPI, Basel, Switzerland. This article is an open access article distributed under the terms and conditions of the Creative Commons Attribution (CC BY) license.